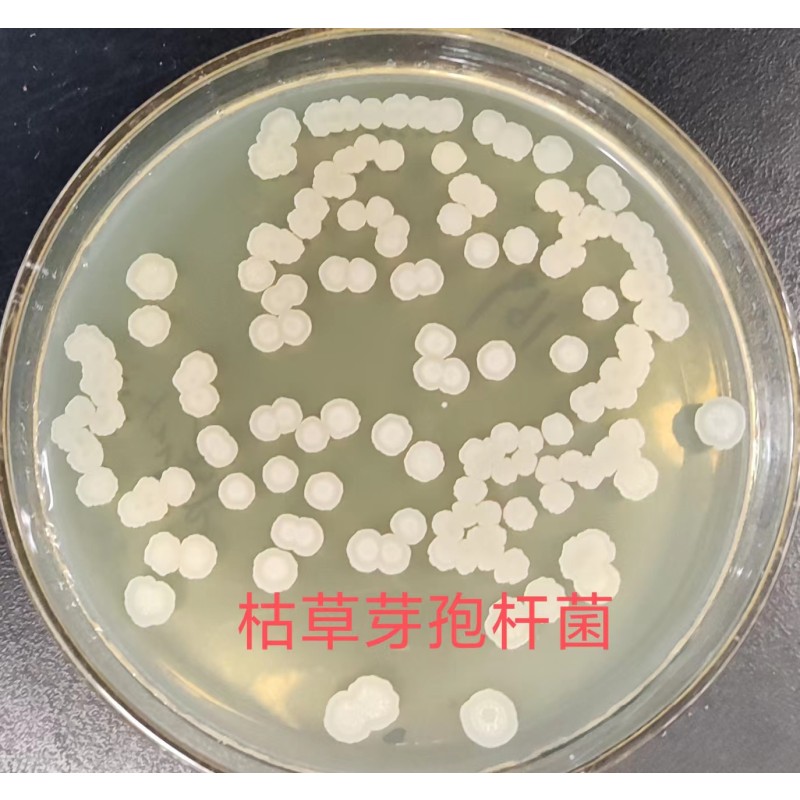
High Quality 20 Billion Bacillus Subtilis Fish Growth Booster Probiotics for Purified Water Quality

- Overview
- Details & Specs
- Related
High Quality 20 Billion Bacillus Subtilis Fish Growth Booster Probiotics for Purified Water Quality
-
US$ 3.5
≥1000
-
US$ 4
100–999
-
US$ 4.5
≤99
Product Attribute
1 years
Product information











Basic Information
- Total Capitalization: NA
- Year Established: NA
- Total Employees: NA
- Product Certificate: NA
- Business Type: Trading Company
Trading Capabilities
- Total Annual Revenue: NA
- Export Percentage: NA
- OEM Services: NA
- Small Orders Accepted: NA
- Brand Names: NA
- Payment Terms: NA
- Main Competitive Advantages: NA
- Major Customer: NA
- Export Markets: NA
Latest Products from this Supplier
-
 Fertilizer Factory Supply Bacillus Licheniformis Buy Bacillus Subtilis
Fertilizer Factory Supply Bacillus Licheniformis Buy Bacillus Subtilis -
 Factory Supply Bacillus Subtilis Spore Powder Bacillus Coagulans White Powder Water Soluble Fertilizer
Factory Supply Bacillus Subtilis Spore Powder Bacillus Coagulans White Powder Water Soluble Fertilizer -
 Shorter Lead Time Bacillus Subtilis for Plant Disease Prevention Bacillus Laterosporus Fertilizer Hydroponic
Shorter Lead Time Bacillus Subtilis for Plant Disease Prevention Bacillus Laterosporus Fertilizer Hydroponic -
 Fast Delivery Bacillus Subtilis Buy Bacillus Pumilus Fertilizer for Vegetables
Fast Delivery Bacillus Subtilis Buy Bacillus Pumilus Fertilizer for Vegetables -
 Factory Supply Bacillus Subtilis Bacillus Mucilaginosus Fertilizer for Tomato
Factory Supply Bacillus Subtilis Bacillus Mucilaginosus Fertilizer for Tomato -
 Flexible Production Bacilius Subtilis Bacillus Megaterium Fertilizer for Rice
Flexible Production Bacilius Subtilis Bacillus Megaterium Fertilizer for Rice -
 Factory Supply Bacillus Subtilis Fiyati Bacillus Coagulans Fertilizer Plant
Factory Supply Bacillus Subtilis Fiyati Bacillus Coagulans Fertilizer Plant -
 Shorter Lead Time Biofertilizer for Concrete Bacillus Laterosporus Fertilizer for Plants
Shorter Lead Time Biofertilizer for Concrete Bacillus Laterosporus Fertilizer for Plants -
 Factory Supply Agricultural Drone Fertilizer Bacillus Mucilaginosus Fertilizer Chemical
Factory Supply Agricultural Drone Fertilizer Bacillus Mucilaginosus Fertilizer Chemical -
 Flexible Production Bacillus Subtilis Liquid Bacillus Megaterium Fertilizantes
Flexible Production Bacillus Subtilis Liquid Bacillus Megaterium Fertilizantes